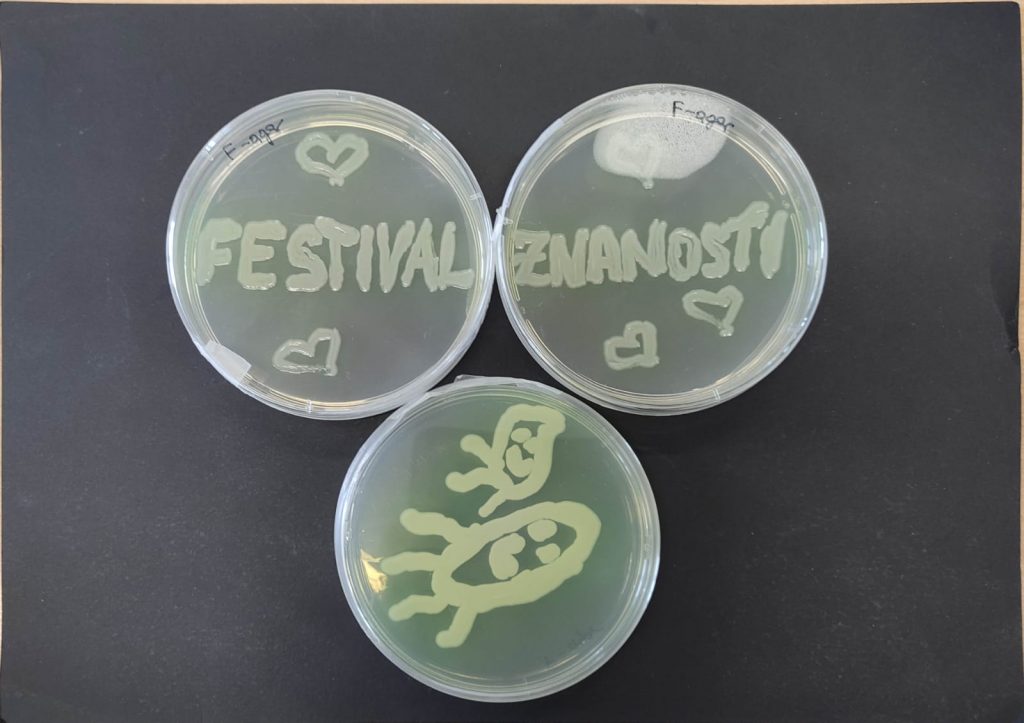

Na Sveučilištu Sjever se od 02. do 07. svibnja 2022. godine održao Festival znanosti na temu „Život“. Članice PERSPIRE tima Ines Sviličić Petrić, Helena Senko i Anastazija Huđ su na Festivalu održale radionicu pod nazivom „Tajni život biljaka – mali (mikro)saveznici koji biljci pomažu da(pre)živi klimatske promjene“ koja je privukla brojne posjetitelje od vrtićke do srednjoškolske dobi.